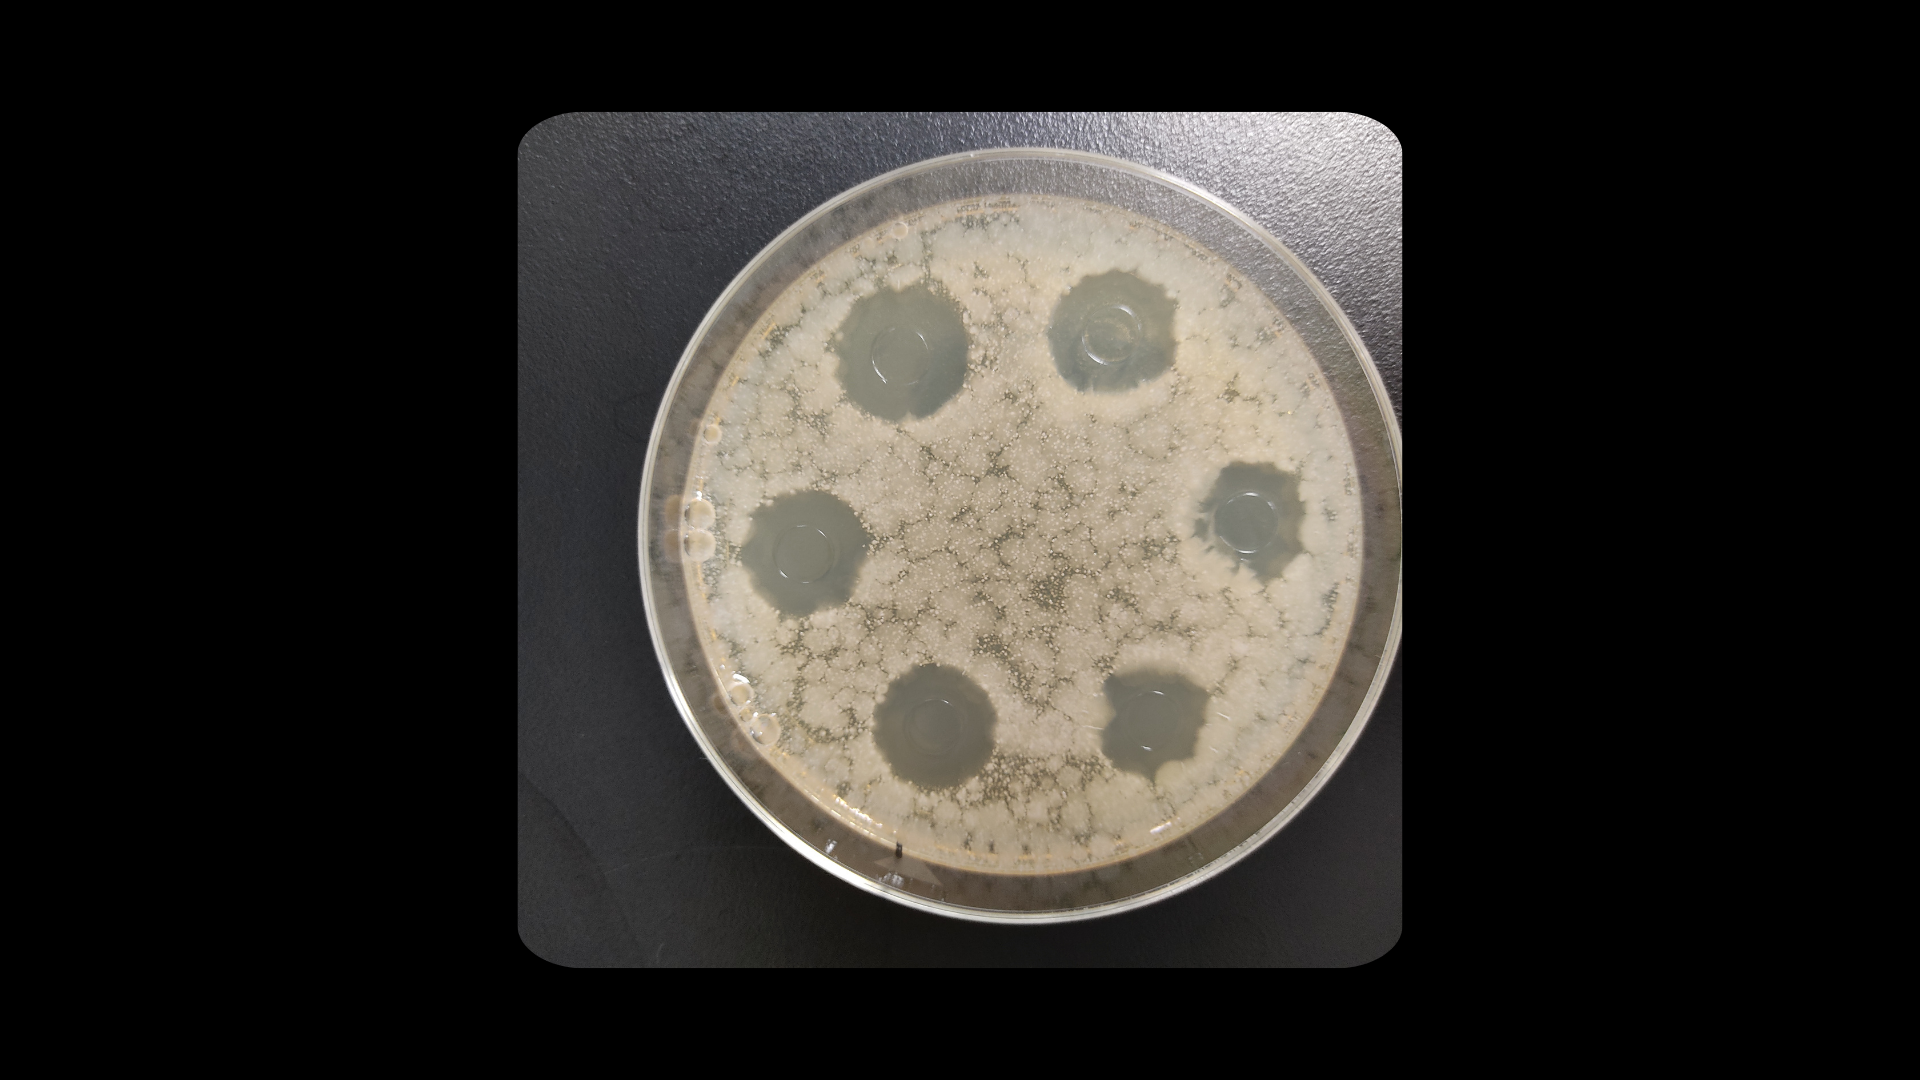

Testing and Certification of Products
Testing and Certification of Products
Compliance with DoD Prohibited Substances
Our products comply with DoD regulations, ensuring they are free of prohibited substances as verified by the OPSS (Operation Supplement Safety). This compliance ensures that our products can be safely used by military personnel, who must adhere to strict substance guidelines to maintain readiness and compliance with military standards.
No Banned Substances
We adhere to regulations against substances like CBD and hemp seeds, ensuring that our products contain no banned substances. This commitment to purity and compliance ensures our supplements are safe and effective for all users, providing peace of mind and guaranteeing that our products meet the highest standards of safety and legality.
Quality Assurance
Through comprehensive testing and rigorous certification processes, 1st Step Pro Wellness ensures that our liquid vitamins are safe, effective, and compliant with the highest standards. Our dedication to quality assurance means you can trust our products to support your health and performance without compromise.